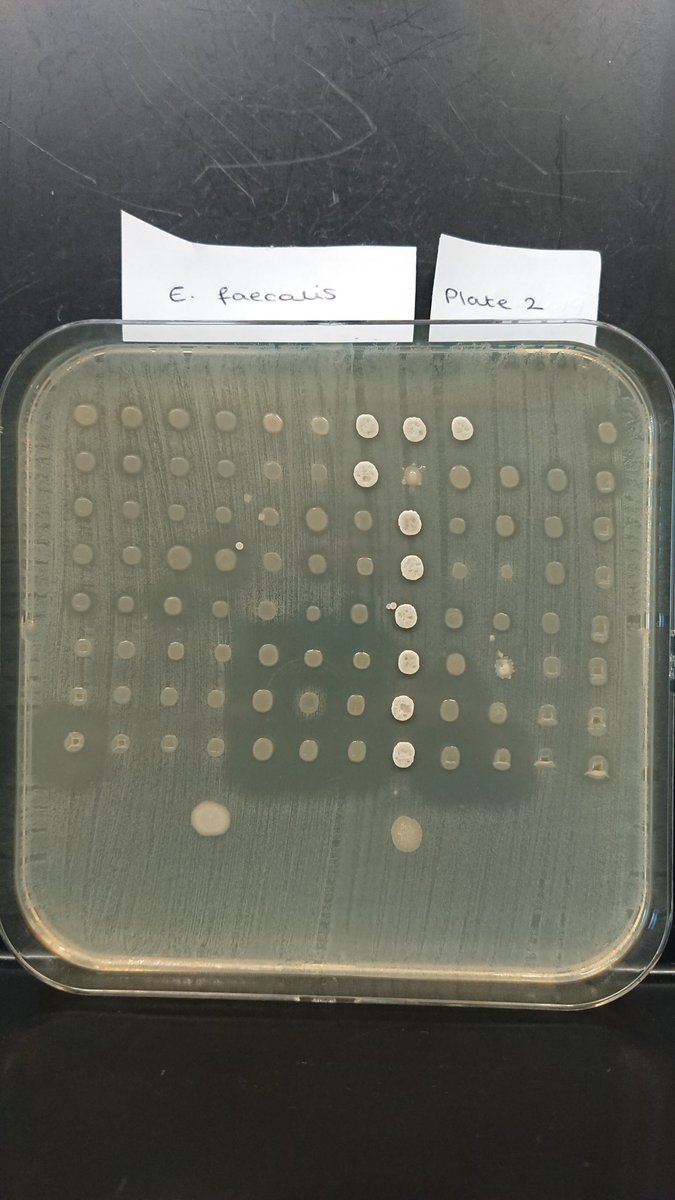
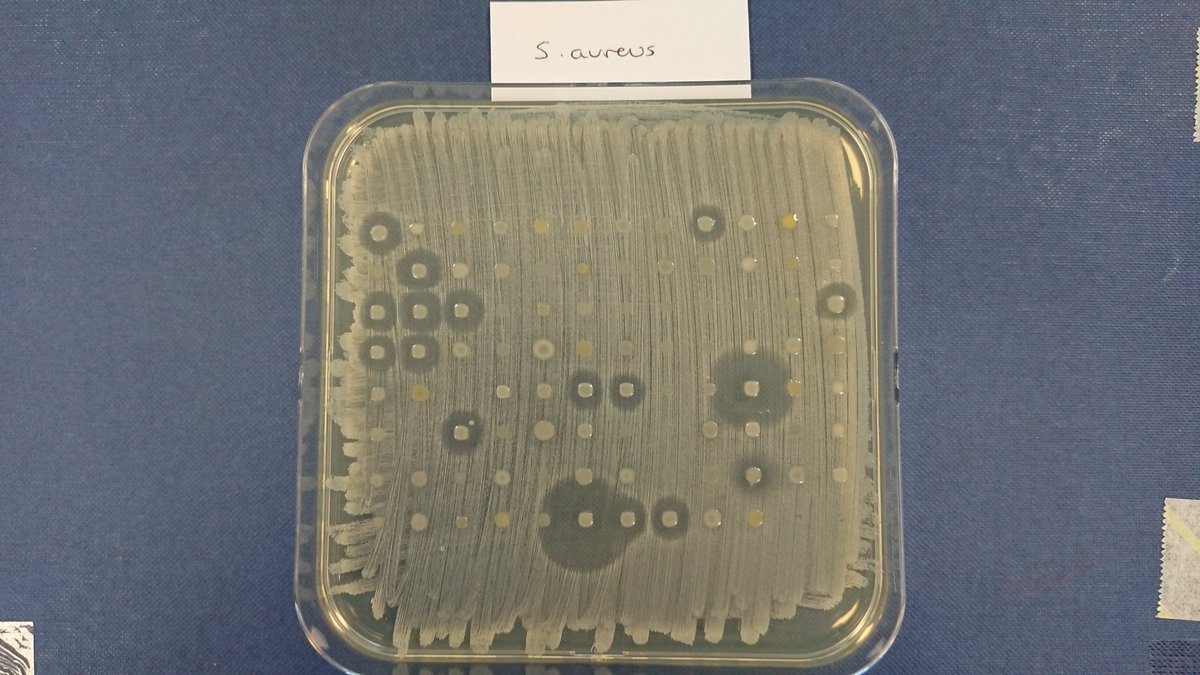

Philip Warburton
@drphilwarburton
Lecturer in microbiology at Plymouth Uni, researcher in AMR and antimicrobials. Avid MR2 AW11 owner, costume and prop maker.
ID: 4066758833
29-10-2015 09:13:53
1,1K Tweet
354 Followers
509 Following



Giving a proactive summer student from University of Surrey a little bit of extra lab experience. Nice to see little details and practices that they learnt during their placement at Porton Down are the same as those I put in place in my lab.




Thanks to the Drake’s Island custodian for granting permission to collect a couple of samples while I was on the Island for the British Fireworks Championship. One sample produced three interesting antibiotic producing bacteria that appear to kill MRSA, that I will follow up on.






Really happy to have won a small grant through the Seale Hayne Educational Trust to continue my Plantimicrobials project searching for novel antibiotics with The Lost Gardens of Heligan.


Great to be involved in this collaboration led by Dr Lee Hutt, with Mat Upton, JazminConway and others, plus some productive University of Plymouth undergraduate students examining bacteria within the Roman Baths The Roman Baths for potential novel antibiotics. sciencedirect.com/science/articl…



Tried to buy a packet of prawn cocktail crisps at my local craft beer place (Vessel Beer Shop) only to be told that someone has already reserved the last two packets....for their dog! Apparently it expects them.